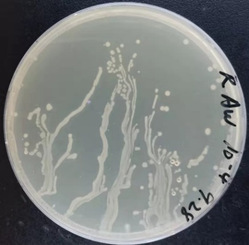

为营造浓郁的学习科研氛围,弘扬学术科研精神,促进研究生德智体美劳全面发展,通过光影语言呈现校区研究生最美科研成果,进一步激发学术兴趣,融洽导学关系,经研究决定,举办首届“最美科研图”主题征集活动,通知如下:
一、 活动主题
发现科研之美,定格精彩瞬间
二、 活动时间
2022年4月18日-5月5日
三、 活动对象
哈尔滨工业大学(威海)在读博士、硕士,本科生。
四、 作品内容
(1)模块一:最美科研瞬间,主要提交科研工作(实验、模拟、结构设计等)中捕捉到的精彩瞬间图片;
(2)模块二:最美复合作图(各种折线图、散点图等复合图)
(3)模块三:最美科研笔记,主要提交科研学习过程中的笔记图、思维导图、框架图等。
五、 作品要求
(1)所提交的作品必须为原创图片,不得抄袭、剽窃、虚假编造等;作品内容应积极健康,富有时代特色和创新精神,不得涉及涉密科研成果,不得损害他人权益。
(2)作品可以通过实验仪器、电脑软件等科研设备获得,也可通过手机、相机、截图等方式获得。不接受视频作品。在不改变作品原貌、原始数据的前提下,可以通过软件进行适当的后期处理。
(3)作品应从以上三个模块中任选其一,也可同时参加,复合作图至少由四幅以上单图组合而成。每件参赛作品都将获得一个编号作为唯一标识。
(4)个人或团队如同时参加三个模块的征集活动,需分别提交作品,每一模块最多提交一幅作品。团队提交作品时注明团队名及所有作者姓名。同时主办方将默认已获得所有作者的知情同意。
(5)作者需按相关要求填写《首届“最美科研图”主题征集活动报名表》上传作品、简介及各项信息。
(6)参赛作品将在哈工大威海研究生会微信公众号进行展示,为保证图片质量,图片分辨率应
600ppi,参选作品的文件类型必须是JPG、TIF或EMF格式。
六、 作品示例

科研瞬间示例展示


复合作图示例展示



笔记、结构图示例展示
本活动最终解释权归哈尔滨工业大学(威海)研究生会所有,投稿者必须确保自己拥有投稿作品著作权、版权,所投稿作品如引起任何著作权、版权纠纷,由投稿者自行承担,与主办方无关。
七、 报名方式
以个人或团体的形式报名,作品作者需准确填写报名表,并在5月5日内将报名表及作品原件打包发送至hitwhylq2020@126.com,参赛作品及邮件主题命名格式为“模块名称+姓名+班级+作品主题”,例如“最美科研瞬间+张三+20级船舶与海洋工程+胖头鱼”。
哈尔滨工业大学(威海)研究生处
共青团哈尔滨工业大学(威海)委员会
哈尔滨工业大学(威海)研究会
2022年4月18日